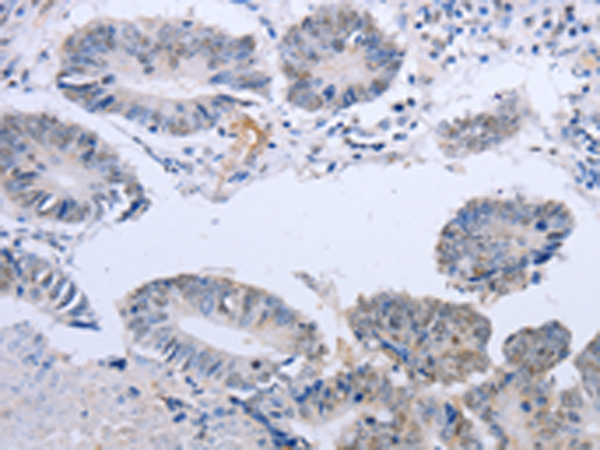
一抗

|
Background: |
The protein encoded by this gene is a member of the DOK family of membrane proteins, which are adapter proteins involved in signal transduction. The encoded protein interacts with phosphorylated receptor tyrosine kinases to mediate neurite outgrowth and activation of the MAP kinase pathway. In contrast to other DOK family proteins, this protein does not interact with RASGAP. |
|
Applications: |
ELISA, IHC |
|
Name of antibody: |
DOK5 |
|
Immunogen: |
Fusion protein of human DOK5 |
|
Full name: |
docking protein 5 |
|
Synonyms: |
C20orf180 |
|
SwissProt: |
Q9P104 |
|
ELISA Recommended dilution: |
1000-2000 |
|
IHC positive control: |
Human colon cancer |
|
IHC Recommend dilution: |
10-50 |

 購物車
購物車 幫助
幫助
 021-54845833/15800441009
021-54845833/15800441009